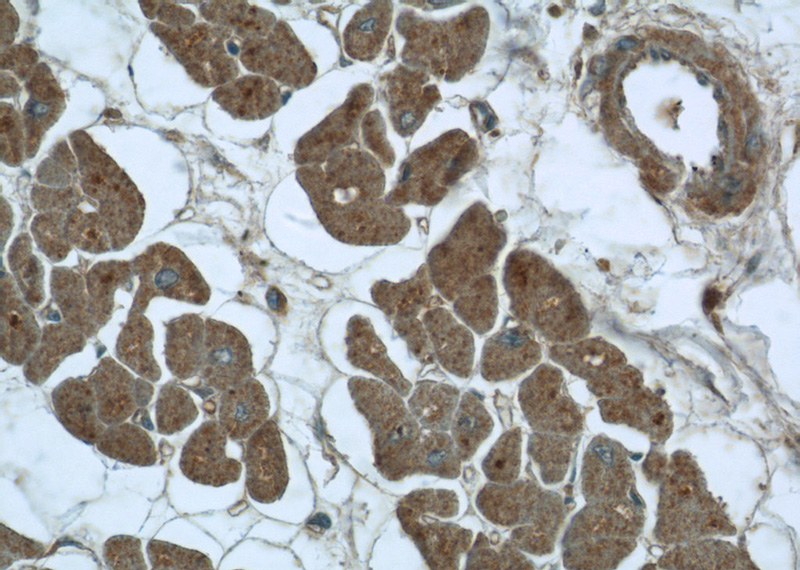
Immunohistochemistry of paraffin-embedded human heart tissue slide using Catalog No:109841(DDX58 Antibody) at dilution of 1:50 (under 40x lens)

-
Product Name
DDX58 antibody
- Documents
-
Description
DDX58 Rabbit Polyclonal antibody. Positive IHC detected in human heart tissue, human colon tissue. Positive WB detected in A431 cells. Positive IP detected in A431 cells. Observed molecular weight by Western-blot: 101 kDa
-
Tested applications
ELISA, WB, IHC, IP
-
Species reactivity
Human; other species not tested.
-
Alternative names
DDX58 antibody; DEAD box protein 58 antibody; DKFZp434J1111 antibody; DKFZp686N19181 antibody; FLJ13599 antibody; RIG 1 antibody; RIG I antibody
-
Isotype
Rabbit IgG
-
Preparation
This antibody was obtained by immunization of DDX58 recombinant protein (Accession Number: NM_014314). Purification method: Antigen affinity purified.
-
Clonality
Polyclonal
-
Formulation
PBS with 0.1% sodium azide and 50% glycerol pH 7.3.
-
Storage instructions
Store at -20℃. DO NOT ALIQUOT
-
Applications
Recommended Dilution:
WB: 1:200-1:2000
IP: 1:200-1:2000
IHC: 1:20-1:200
-
Validations

A431 cells were subjected to SDS PAGE followed by western blot with Catalog No:109841(DDX58 Antibody) at dilution of 1:600

IP Result of anti-DDX58 (IP:Catalog No:109841, 4ug; Detection:Catalog No:109841 1:600) with A431 cells lysate 1200ug.

Immunohistochemistry of paraffin-embedded human heart tissue slide using Catalog No:109841(DDX58 Antibody) at dilution of 1:50 (under 10x lens)
Immunohistochemistry of paraffin-embedded human heart tissue slide using Catalog No:109841(DDX58 Antibody) at dilution of 1:50 (under 40x lens)
-
Background
DDX58, also named as RIG-1, belongs to the helicase family. It is involved in innate immune defense against viruses. Upon interaction with intracellular dsRNA produced during viral replication, triggers a transduction cascade involving MAVS/IPS1, which results in the activation of NF-kappa-B, IRF3 and IRF7 and the induction of the expression of antiviral cytokines such as IFN-beta and RANTES (CCL5). Detects dsRNA produced from non-self dsDNA by RNA polymerase III, such as Epstein-Barr virus-encoded RNAs (EBERs). It is essential for the production of interferons in response to RNA viruses including paramyxoviruses, influenza viruses, Japanese encephalitis virus and HCV.
Related Products / Services
Please note: All products are "FOR RESEARCH USE ONLY AND ARE NOT INTENDED FOR DIAGNOSTIC OR THERAPEUTIC USE"
